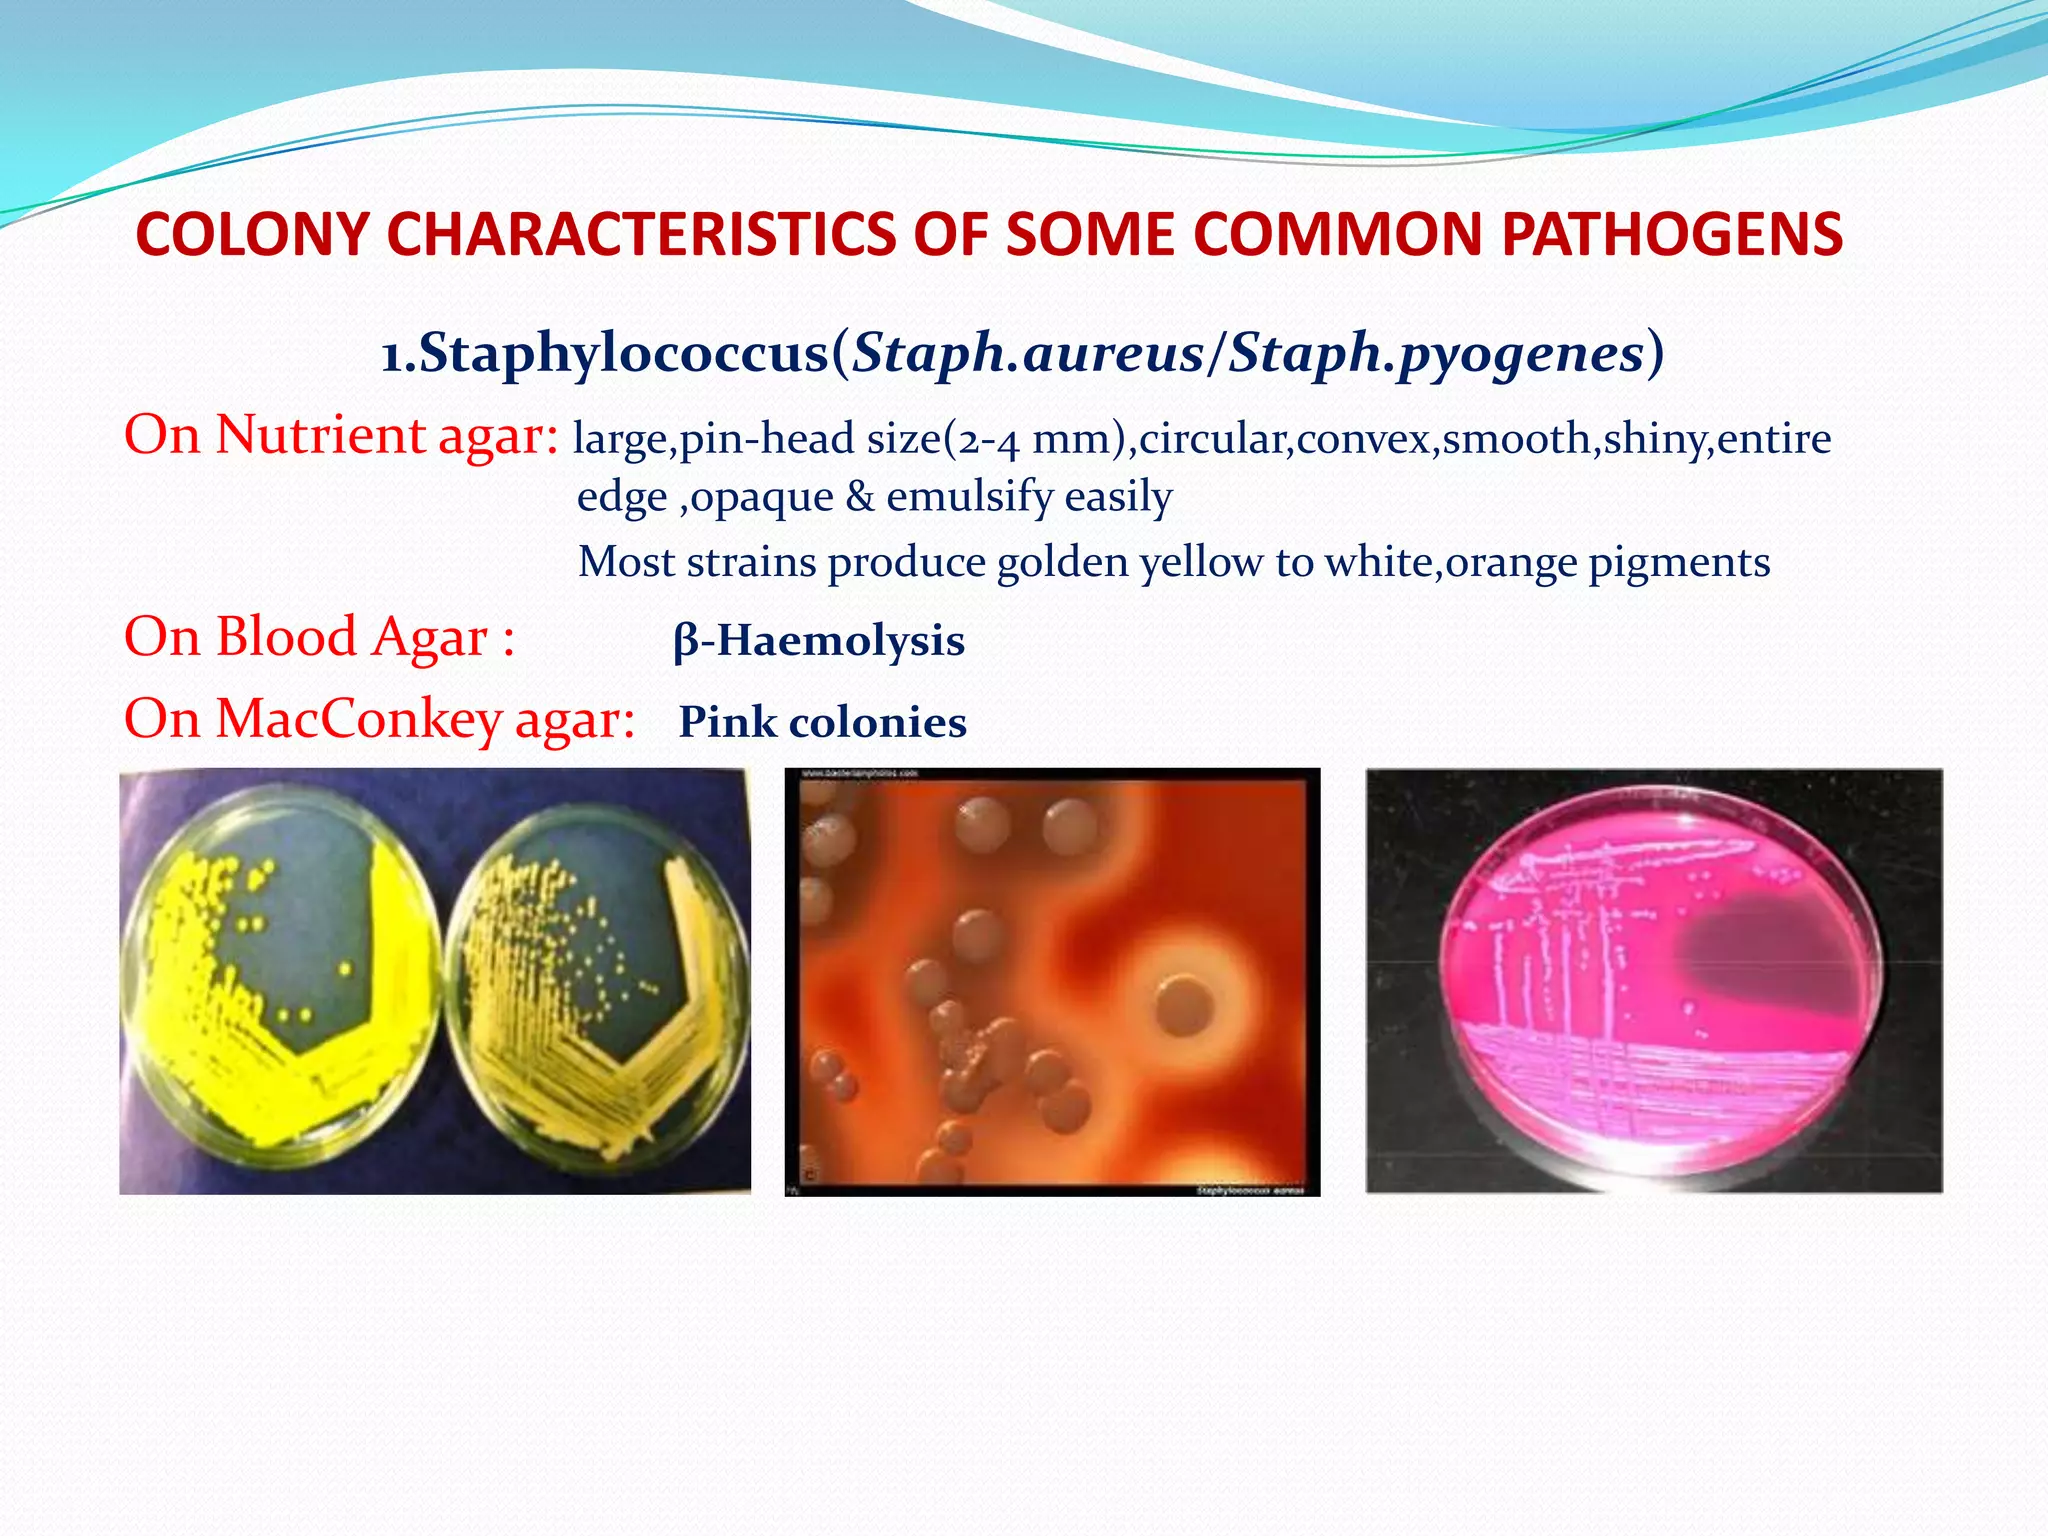
How to read a culture plate | PPTX

Define elegance through vast arrays of style-focused what is a staphylococcus culture plate at vivian carter blog photographs. elegantly highlighting truck, vehicle, and automobile. designed to inspire fashion choices. Our what is a staphylococcus culture plate at vivian carter blog collection features high-quality images with excellent detail and clarity. Suitable for various applications including web design, social media, personal projects, and digital content creation All what is a staphylococcus culture plate at vivian carter blog images are available in high resolution with professional-grade quality, optimized for both digital and print applications, and include comprehensive metadata for easy organization and usage. Discover the perfect what is a staphylococcus culture plate at vivian carter blog images to enhance your visual communication needs. Advanced search capabilities make finding the perfect what is a staphylococcus culture plate at vivian carter blog image effortless and efficient. Diverse style options within the what is a staphylococcus culture plate at vivian carter blog collection suit various aesthetic preferences. Time-saving browsing features help users locate ideal what is a staphylococcus culture plate at vivian carter blog images quickly. The what is a staphylococcus culture plate at vivian carter blog archive serves professionals, educators, and creatives across diverse industries.